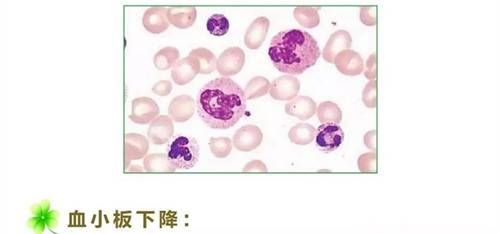
5.jpg

乐观应对化疗不良反应(上篇)

顺铂和蒽环类药物较重,目前所有患者化疗期间均常规采用预防止吐,个别患者反应较重时需采用不同机制止吐药物联合应用,经常规处理,绝大多数患者能够达到无明显恶心呕吐。

部分药物如紫杉类和长春瑞滨有一定比例的肠道症状,如出现腹泻或便秘,多数较轻,给予对症支持治疗即可好转。

迅速增殖的粘膜组织容易受到化疗药物损伤,表现为口腔粘膜疼痛、部分可出现溃疡,常见于甲氨喋呤和氟尿嘧啶类药物。
出现口腔粘膜炎患者,可应用漱口液(预防细菌及真菌感染)、进食前含漱利多卡因液止痛、给予维生素B2等多种维生素、必要时给予静脉营养支持治疗。

最常见。
粒细胞的半衰期最短,约6~8小时,因此最先下降,最低值一般出现在化疗后7~13天,白细胞及粒细胞下降的治疗疗效很好,以粒细胞集落刺激因子为主。
个别药物有血小板下降的不良反应,轻度下降不需处理,较重时可采用血小板集落刺激因子、输血小板等措施,Ⅳ度以下血小板降低患者需适当制动。

临床表现为血清谷丙、谷草转氨酶升高或血清胆红素升高。
化疗期可常规预防或治疗性使用保肝药物,严重时需停用化疗。

轻度损害临床上可无明显症状而表现为肌酐升高、轻度蛋白尿、镜下血尿;严重则可出现肾功能衰竭。
肾脏毒性以预防为主。
绝大多数化疗药物的肾毒性不明显,顺铂和甲氨喋呤相对多见。
因此顺铂应用时常规水化、利尿并计24小时尿量以减轻药物对肾脏的影响。

紫杉类药物和长春瑞滨、奥沙利铂(避免接触凉物,饮用冷水)多见未梢神经病变,表现为肢端(手指、脚趾常见)麻木、疼痛等,顺铂可见听神经改变,表现为耳鸣、听力下降等,多数不严重,可继续治疗,不能耐受时停药多数可自行恢复。
应用营养神经药物可减轻症状。

临床表现为脱发(通常是可逆的)、皮肤色素沉着、皮疹及手足综合征(希罗达、5-FU),这类反应影响美观,绝大多数可逆,停药后逐渐恢复。

少数药物可致速发性过敏反应,因此常规给予预处理,如多西紫杉醇和紫杉醇治疗前后常规预防应用激素,防止过敏反应发生。
——未完待续
收藏
回复(16)参与评论
评论列表






